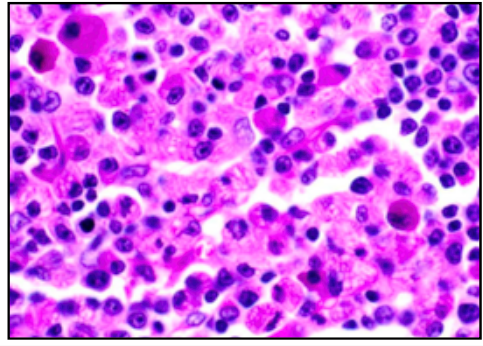

What is this?

ALCIAN BLUE
- GAG-rich
- mucous
- mast cells
- cartilage
BLUE
What is this?

EOSIN
- colloidal proteins
- plasma
PINK
EOSINOPHILIC = ACIDOPHILIC
What is this?

IRON HAEMATOXYLIN
- nuclei
- elastic fibres
BLACK
What is this?
PERIODIC ACID SCHIFF (PAS)
- hexose sugars (complex carbs)
- goblet cell mucins
- cartilage matrix
- glycogen
- basement membranes
- brush border
MAGENTA (DARK PINK)
What is this?

ROMANOVSKY/LEISHMANN’S (BLOOD FILMS)
- Chromatn/nuclei and neutrophil granules (PURPLE)
- eryhtrocytes/eosin granules (RED/PINK)
- lymphocyte/monocyte plasma (PALE BLUE)
- basophil granules (DARK BLUE/PURPLE)

TOLUIDINE BLUE
- nuclei/ribosomoes (DARK BLUE)
- cytoplasm (PALE BLUE)
- cartilage/matrix/mast cell/GAG rich (BRIGHT PURPLE)

VAN GIESON’S TRICHROME WITH HAEMATOXYLIN COUNTER STAIN
- collagen (PINK RED)
- cell cytoplasm (YELLOW/OLIVE GREEN)
- nuclei (BLACK)
- elastic tissue (DARK BROWN)

HAEMATOXYLIN
- nuclei
- RNA
BLUE
BASOPHILIC STRUCTURES = BLUE

SILVER STAIN - NEURONS
- neurons are large
- 25-60 microns
- because of slide thickness you cannot see all processes
- 1-5 dendritic processes
- metabolically active
- fully differentiated

LYMPHOCYTE SIZE
- small = 5 microns
- little cytoplasm as dormant and not fully differentiated
- metabolically inactive
- minimal rER

EPITHELIA
- barries
- single layer = simple
- multi layer = stratified
- stratified = protection

SIMPLE COLUMNAR
- height > width
- oval nucleus
- longer axis perp. to base of cell
- often microvilli or cilia at apical membrane
- GUT ENTEROCYTES and RESPIRATORY TRACT
left = gallballder

INTESTINAL EPITHELIUM
- enterocytes w/ goblet cells
- epithelia sit on BM - permeability barrier between epithelium and connective tissue
- microvilli at apical surface = BRUSH BORDER
- brush border - increase SA / attachment of exo-enzymes
- samll intestine = simple columnar

MICROVILLI/INTESTINAL WITH PAS AND HAEMATOXYLIN
- microvilli with carb. rich GLYCOCALYX
- goblet cells and BM rich in HEXOSE
- stain magenta

CILIATED SIMPLE COLUMNAR EPITHELIUM
- nose/larynx/bronchial tree/fallopian tube
- SIMPLE COLUMNAR EP w/ goblet cells and cilia
- cilia = 2 microns
LEFT = NOSE
stained with H&E and ALCIAN BLUE
cilia movement by tubulin and dynein

CUBOIDAL EPITHELIUM
- square
- round nucleus
- @ducts of exocrine glands - sweat glands, salivary, pancreas
- kidney tissue

SQUAMOUS
- outer surface of most thoracic and abdominal organs
- simple squamous epithelium (SEROSA)
- also lines pleural and peritoneal cavities
- air sacs of lungs (alveoli)
- FLATTENED
- CYLINDRICAL/ELLIPTICAL NUCLEI @ base of cell
LEFT = serosa @ outer wall intestine

AIR / BLOOD BARRIER
- septa = capillaries covered by simple squamous ep
- typically 1 micron
- overall thickness = 5-10 microns
- with 2x capillary endothelial cells, 2x T1 pneumocytes and capillary lumen

STRATIFIED SQUAMOUS
- mouth, throat, oesophagus, anus, vagina
- cells replaced from below
- stem cells (mitosis capable) at basal layer
- sloughed off from top
this slide = moist non-keratinised stratified squamous epithelium at mouth
(moist from glandular secretion)

KERATINISED STRATIFIED SQUAMOUS
- epidermis
- lower layers epidermis similar to stratified squamous
- upper layers syntehsise unique collection of proteins - interact with cytoskeleton of cell to produce keratin
- keratine - dense protein, fills cytoplasm of cells = tough and waterproof
- when full of keratin cells die and are sloughed off
this slide - hairless skin @ lower lip
blue/purple = living
pink = dead keratinised squames
@ boundary =layer with blue keratohyaline granules
STRATUM GRANULOSUM - intermediate with blue grans
STEM CELLS @ basal layers

PSEUDOSTRATIFIED
- multilayered but when stretched flattens
- TRACHE AND BRONCHI
- @urinary tract = specialised UROTHELIUM
distinguish from stratified
all cells in contact with BM
cells replaced by lateral migration not vertical
this slide - trachea

CELL JUNCTIONS
- bound tightly together to prevent macromolecule or fluid movement
- DESMOSOMES
- TIGHT (ADHERENT) JUNCTIONS
- GAP JUNCTIONS

GLANDS
- epithelial in origin - develop as ingrowths
- exocrine glands to surface by ducts
- fluid, lubricants, enzymes
MUCUS - separate acini from serous, occasionally mixed
PALE - flattened nucleus at base of cell
SEROUS
DARK - round nuclei

CONNECTIVE TISSUE - INTRO
- extracellular fibre scaffold - COLLAGEN/ELASTIN
- jelly-like matrix - hydrophilic polysaccharide polymer - GAG - glycosaminoglycans
- GAG - synthesises @ epithelial cells, muscle, cartilage, bone
- COLLAGEN/ELASTIN synthesised by fibroblast



















